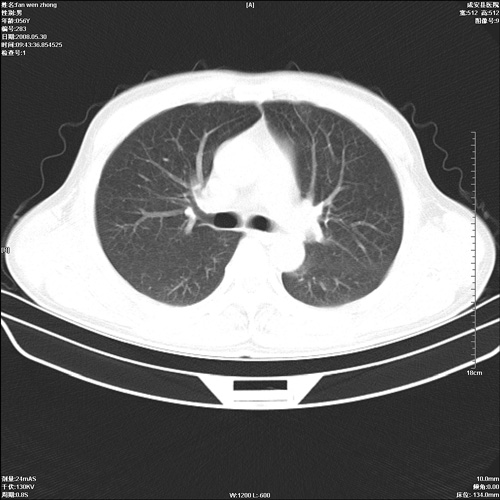

医影在线
标题: CT13764:胸部 [打印本页]
作者: 还珠格格 时间: 2008-6-1 00:12
标题: CT13764:胸部
病人 男 56岁 一周前高热,体温达39-40度,经抗炎治疗后,体温渐降,达37,5-38度,轻微咳嗽,胸部不适 查白细胞为1.3万 行ct检查,请分析。
































[本贴已被 还珠格格 于 2008-5-31 16:14:51 修改过]
[本贴已被 翁志蓬 于 2008-5-31 17:32:39 修改过]
作者: 深泽交通 时间: 2008-6-1 00:21
转移瘤,韦氏肉呀肿待除;感染灶
作者: ydx_74 时间: 2008-6-1 00:33
肺部感染,结核可能大。金葡不像。
作者: 影象小辈 时间: 2008-6-1 00:36
首先考虑转移瘤
作者: lrj 时间: 2008-6-1 00:39
本人倾向于双肺感染性病变,血源性肺脓肿待排除;请结合临床,建议抗炎后复查
作者: ※学生※ 时间: 2008-6-1 00:47
肺部感染性病变 首先考虑金葡菌感染不除外血缘性肺脓肿可能
作者: 随光逐影 时间: 2008-6-1 01:07
考虑为:两肺感染性病变(金葡?)。建议:抗炎治疗后复查。
作者: 358450m 时间: 2008-6-1 01:24
标题: 回复:胸部
以下是引用※学生※在2008-5-31 16:47:00的发言:[br]肺部感染性病变 首先考虑金葡菌感染不除外血缘性肺脓肿可能
作者: caihe 时间: 2008-6-1 01:33
该病例虽然血象高,一周前高热。警惕!不能除外右肺周围型肺癌并肺内转移。一定要作胸穿、病理检查,以便确诊。或继续抗炎治疗后复查ct。
作者: 光影相伴 时间: 2008-6-1 01:37
两肺感染性病变(金葡?)。
作者: 沉默是金 时间: 2008-6-1 01:39
考虑韦格氏肉芽肿
作者: yangyudong333 时间: 2008-6-1 01:49
考虑右肺周围型肺癌并双肺转移
作者: 老爱克斯 时间: 2008-6-1 01:53
双肺内可见多发结节状病灶,并见小空洞,病人高热,白血球增高,应该是典型的迁徙性肺脓肿(多为金黄色葡萄球菌感染)。查一下口腔等其它部位有无感染灶。
作者: hjk 时间: 2008-6-1 02:36
双肺感染性病变,霉菌可能,建议查痰
作者: XIANXIANZHONGYI 时间: 2008-6-1 02:58
标题: 回复:ct13764:胸部
以下是引用老爱克斯新网客在2008-5-31 17:53:00的发言:[br]双肺内可见多发结节状病灶,并见小空洞,病人高热,白血球增高,应该是典型的迁徙性肺脓肿(多为金黄色葡萄球菌感染)。查一下口腔等其它部位有无感染灶。
支持
作者: 拾荒者 时间: 2008-6-1 03:28
标题: 回复:ct13764:胸部
以下是引用老爱克斯新网客在2008-5-31 17:53:00的发言:[br]双肺内可见多发结节状病灶,并见小空洞,病人高热,白血球增高,应该是典型的迁徙性肺脓肿(多为金黄色葡萄球菌感染)。查一下口腔等其它部位有无感染灶。
韦格肉芽肿待排。建议抗炎治疗后复查。
作者: 杀毒软件 时间: 2008-6-1 04:35
两肺感染性病变
作者: zsl6918 时间: 2008-6-1 05:45
提示霉菌感染
作者: wqs571018 时间: 2008-6-1 05:56
1、血缘性肺脓肿可能;2、血播性肺结核待排除。
作者: jing 时间: 2008-6-1 06:12
双肺感染性病变,霉菌可能,建议查痰
作者: pujunzhi 时间: 2008-6-1 06:18
肺脓肿可能性大,不除外转移瘤和韦氏肉芽肿。
作者: zhangnianqiu_20 时间: 2008-6-1 06:30
考虑血源性肺脓肿,建议抗炎治疗后复查。
作者: xn2ylwg 时间: 2008-6-1 08:03
双肺内可见多发结节状病灶,并见小空洞,病人高热,白血球增高,应该是典型的迁徙性肺脓肿(多为金黄色葡萄球菌感染)。建议治疗后复查.
作者: xulianj 时间: 2008-6-1 17:21
双肺内可见多发结节状病灶,并见小空洞,病人高热,白血球增高,应该是典型的迁徙性肺脓肿(多为金黄色葡萄球菌感染)。查一下口腔等其它部位有无感染灶。
作者: zjzjr 时间: 2008-6-1 18:55
支持金葡菌肺炎.
作者: liuyue 时间: 2008-6-2 00:58
双肺内可见多发结节状病灶,并见小空洞,病人高热,白血球增高,应该是典型的迁徙性肺脓肿(多为金黄色葡萄球菌感染)。
支持 !
作者: shuqiang1 时间: 2008-6-2 01:15
标题: 回复:ct13764:胸部
以下是引用caihe在2008-5-31 17:33:00的发言:[br]该病例虽然血象高,一周前高热。警惕!不能除外右肺周围型肺癌并肺内转移。一定要作胸穿、病理检查,以便确诊。或继续抗炎治疗后复查ct。
支持转移瘤!
作者: 黑白光影 时间: 2008-6-2 03:41
肺部感染性病变 首先考虑金葡菌感染不除外血缘性肺脓肿可能。
作者: dr.yang 时间: 2011-12-8 23:13
双肺内可见多发结节状病灶,并见小空洞,病人高热,白血球增高,应该是典型的迁徙性肺脓肿(多为金黄色葡萄球菌感染)。查一下口腔等其它部位有无感染灶。
| 欢迎光临 医影在线 (http://bbs.radida.com/bbs/) |
Powered by Discuz! X3.2 |